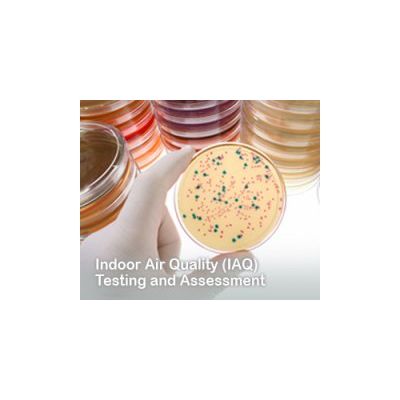

- Home
- Companies
- Germguard Technologies (M) Sdn Bhd
- Services
- Indoor Air Quality (IAQ) Testing and ...
Indoor Air Quality (IAQ) Testing and Assessment Services
This has given the company utmost flexibility to carry out IAQ services in multiple locations at any one time. Germguard has undertaken more than 3.15 million sq. ft. of comprehensive decontamination of fungal and infection control measures at buildings and healthcare facilities. This is a testimony to our clients’ confidence in Germguard’s competency as the Leader in providing IAQ solutions in the region.
Germguard is an ISO 9001:2008 (Provision of Indoor Air Quality Services) company, accredited by UKAS and The Department of Standards, Malaysia. We are the first in Malaysia to be certified as an Air System Cleaning Specialist (ASCS) by the National Air Duct Cleaners Association, USA and subscribe to the systems and processes of the Indoor Air Quality Association & Restoration Industry Association of the USA.
Solutions Offered:
- Comprehensive 11 Parameters IAQ Testing
- Surface Testing & Analysis
- Facility Walk-Through
- Evaluation & Building Diagnostics
- HVAC & Air Duct Conditional Appraisal Utilizing Advanced Digital Robotic Technology
- Hygrothermal Mass Diffusion Analysis (Thermography)
- IAQ Assessment And Diagnosis Reporting

